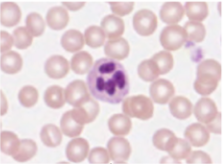
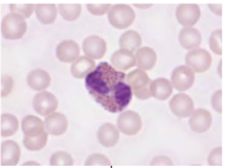
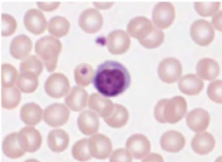
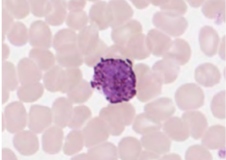
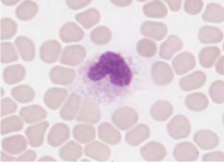

Gross Anatomy - Practicum 1
1/172
There's no tags or description
Looks like no tags are added yet.
Name | Mastery | Learn | Test | Matching | Spaced |
|---|
No study sessions yet.
173 Terms
anatomical position
standing upright, gaze is straight and ahead, feet facing forwards, palms face forwards, fingers pointed downwards

sagittal plane (midsagittal, parasagittal)
vertical plane that divides the body into right and left sections

coronal/frontal plane
vertical plane that divides the body into anterior and posterior portions

transverse plane
horizontal plane that divides the body into superior and inferior parts


identify the plane of the eye
parasagittal

label anatomical regions

label anatomical regions

A ____ MRI shows half the abdomen, pelvis, and vertebral column, the rectum, and the intestines.
midsaggital

A ____ MRI illustrates the front aspect of the thorax, the heart, lungs, liver, stomach, and spleen
coronal

A ____ MRI through the abdomen shows the liver, spinal, aorta, pancreas, and spleen
transverse

The MRI of the vertebral column of the lumbar region above is in a ____ section showing a herniated disc
saggital

By convention, a ____ section such as this is shown with the patient lying on his-her back and viwed from the feet towards the head
transverse

The x-ray of the right knee above shows a total knee replacemnet with prosthesis implant. What view is this presentation?
coronal
label the five cavities that contain the organs of the body

identify the organs from the abdominal cavity

identify the division of the thoracic cavity


list all structures in the RUQ
liver, gallbladder, right kidney, head of pancreas, duodenum, hepatic flexure of transverse colon

list all structures in the LUQ
stomach, spleen, body/tail of pancrea, left kidney, left olobe of liver, splenic flexure of colon

list all structures RLQ
ascending colon, appendix, cecum, small intestine (ileum), R ureter, urinary bladder, rectum, R ovary/fallopian tube, R spermatic cord

descending colon, sigmoid colon, small intestine, L ureter, L ovary/fallopian tube, L spermati cord

list structures found in the right hypochondriac region
R portion of liver, gallbladder, R kidney, duodenum of small intestine, head of pancreas, ascending + hepatic flexure + transverse colon

list structures of the epigastric region
stomach, liver, head/body of pancreas, duodenum, transverse colon, R/L ureters, part of spleen

list structures of the left hypochondriac region
stomach, spleen, tail of pancreas, L kidney, transverse + splenic flexure + descendning colon, left lobe of liver

list structures of the right lumbar region
ascending colon, R kidney, small intestine

list structures of the left lumbar region
descending colon, L kidney, small intestine (jejunum), diaphragm

list structures of the umbilical region
small intestine, transverse colon, stomach, kidneys, head of pancreas, ureters

list structures of the right iliac region
cecum, appendix, ascending colon, R ureter, R ovary/fallopian tube

list structures of the hypogastric region
ilieum of small intestine, sigmoid colon, rectum, urinary bladder, R/L ureters, uterus, ovaries, prostate gland

list structures of the left iliac region
descending + sigmoid colon, small intestine, L ovary/fallopian tube, L ureter

identify CT
blood

identify CT
dense regular

identify CT
dense irregular

identify CT
adipose

identify CT
cartilage

identify CT
bone

identify area of histological slide, type of CT, and identify structures
epidermis, loose CT, lamina propria

identify area of histological slide, type of CT, and identify structures
dermis, loose CT, adipocytes/blood cells

identify area of histological slide, type of CT, and identify structures
reticular dermis, dense irregular, blood vessels/irregular fibers/fibrocytes

identify area of histological slide, type of CT, and identify structures
periodontal ligament, dense regular, fibrocyte in DR/osteocyte in lacunae

identify area of histological slide, type of CT, and identify structures
spleen, reticular fiber, reticulocytes (dark ovals)/reticular fibers

identify area of histological slide, type of CT, and identify structures
aorta, elastic CT, fibrocytes (oval nuclei)/elastic fibers (dark black lines)/smooth muscle (dark staining, flat nuclei)
identify the leukocyte
neutrophil
identify the leukocyte
eosinophil
identify the leukocyte
lymphocyte
identify the leukocyte
basophil
identify the leukocyte
monocyte

identify area of histological slide, type of CT, and identify structures
lamellar bone, bone, osteon/osteocytes (tiny ovals)

identify area of histological slide, type of CT, and identify structures
hyaline cartilage, specialized CT, lucanae/chondrocyte

identify area of histological slide, type of CT, and identify structures
adipose tissue, specialized CT, adipocyte/nuclei (paink staining)

identify area of histological slide, type of CT, and identify structures
bone marrow, unilocular adipose CT, adipocytes/nucleus

identify the surface specialization
stereocilia

identify the surface specialization
microvilli

identify the surface specialization
keratin

identify the surface specialization
cilia

name the type of gland
simple tubular

name the type of gland
simple coiled tubular

name the type of gland
simble branched tubular

name the type of gland
simple alveolar (acinar)

name the type of gland
simple branched alveolar (acinar)

name the type of gland
compound tubular

name the type of gland
compound alveolar (acinar)

name the type of gland
compound tubuloalveolar (tubuloacinar)

identify the type of epithelium
simple cuboidal

identify surface specialization
cilia

identify type of exocrine gland
simple coiled tubular

identify type of epithelium
simple columnar

identify type of epithelium
stratified squamous

label the layers of the integument
epidermis, dermis (papillary layer, reticular layer), hypodermis

identify all layers of thick skin
stratum corneum, stratum lucidum, stratum granulosum, stratum spinosum, stratum basale

identify all layers of thin skin
stratum corneum, stratum granulosum, stratum spinosum, stratum basale

identify the layers of the dermis
papillary layer (loose areolar CT), reticular layer (dense irregular)

layer the dermis + associated structures
dermal papilla, tactile (Meissner’s) corpuscle, free nerve ending, papillary layer, reticular layer, blood vessel, hair follicle, lamellar (Pacinian) corpuscle

identify layer of the skin
hypodermis

what this
apocrine sweat gland (simple coiled tubular gland)

what this
eccrine sweat gland (simple coiled tubular gland)

what this
sebaceous gland (branched alveolar/acinar gland)

wha this
hair follicle

what this
tactile (Meissner’s) corpuscle

what this
lamellar (Pacinian) corpuscle

label the glands
apocrine, sebaceous, eccrine

identify structure
eccrine sweat gland

identify structure
thin skin; stratum corneum; keratinized stratified squamousepithelium

identify the structure
sebaceous gland

identify the structure
lamellar (Pacinian) corpuscle

identify all layers of thick skin
stratum corneum, stratum lucidum, stratum granulosum, stratum spinosum, stratum basale, papillary dermis, reticular dermis, hypodermis

label sensory neuron
sensory nerve endings in periphery, nerve fiber w myelin sheath, cell body, synaptic terminals in CNS

label glial cells
gray matter —> astrocyte, neuron cell body, oligodendrocyte

whats this
cerebrum (white/gray matter)

label cells of the cerebellum


whats this
central canal of spinal cord (filled w csf + lined w ependymal cells)

label spinal cord


what’s this + layers
peripheral nerve (epineurium, perineurium, endoneurium)

what type of neural tissue is this
nerve

what type of neural tissue is this
cerebrum

what type of neural tissue is this
cerebellum

label the general structures of the brain


label ventricles within the brain


label primary cortical areas of the brain


label structures of the diencephalon


label structures on midsagittal section of brain
